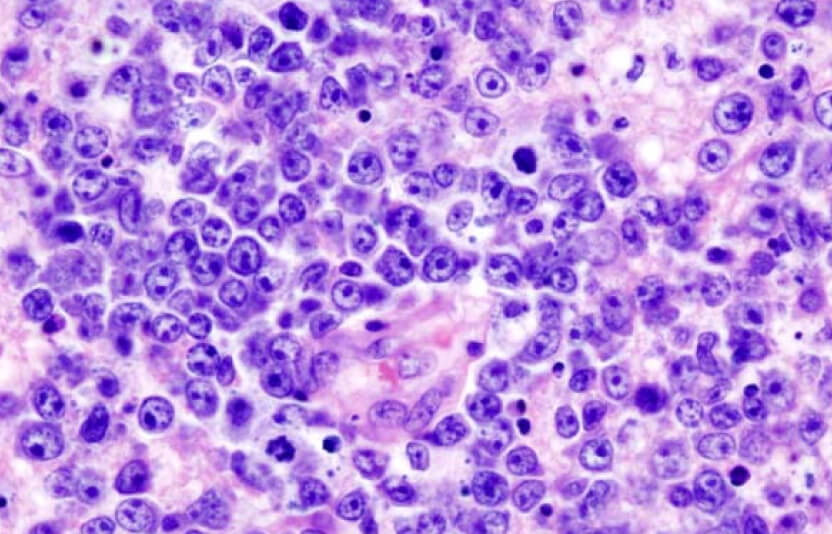
картинка лимфомы

Диагноз «рак» звучит как приговор. Владельцы падают духом, потому что дома диагноз рака часто означает смерть. Им кажется, что у их питомца нет шансов. И я понимаю эту логику. Рак агрессивен. Рак коварен. Рак часто выигрывает.
В этой статье я расскажу вам всё о химиотерапии для животных: как она работает, какие препараты используются, какие побочные эффекты возможны и как она может спасти жизнь вашей собаки или кошки. И самое главное, я объясню, почему в ветеринарной онкологии мы не гонимся за излечением, а стремимся к качеству жизни.
Автор: Варвара Горичкина, ветеринарный врач-терапевт и офтальмолог, «Laska Pets»

Что такое химиотерапия: война с раком на молекулярном уровне
Химиотерапия — это использование химических препаратов, называемых цитостатиками и цитотоксинами, для уничтожения раковых клеток или замедления их роста.
Вот как это работает. Раковые клетки отличаются от здоровых клеток одной главной характеристикой: они делятся бесконтрольно. В то время как здоровая клетка имеет встроенные механизмы, которые говорят ей: "Стой, ты разделилась достаточно," раковые клетки не слушают эти сигналы. Они просто продолжают делиться, делиться, делиться.
Цитостатические препараты воздействуют на процесс клеточного деления. Они блокируют ДНК, препятствуют синтезу белков, нарушают метаболизм клеток. Результат: раковые клетки перестают делиться или умирают.
Здоровые клетки тоже делятся, но медленнее. Поэтому они менее чувствительны к этим препаратам. Это дает нам терапевтическое окно — пространство, в котором мы можем убить раковые клетки и относительно сохранить здоровые клетки.
Ключевое слово здесь — "относительно." Это не идеальное лечение. Побочные эффекты возможны. Но они управляемы, и в большинстве случаев минимальны.
Основные препараты для химиотерапии собак и кошек
В ветеринарной онкологии используются те же препараты, что и в человеческой медицине, но в дозировках и схемах, адаптированных для животных. Основные препараты, которые я использую:
Доксорубицин (Адриамицин)
Это один из самых важных препаратов в нашем арсенале. Доксорубицин является антибиотиком, который воздействует на ДНК раковых клеток.
Я использую доксорубицин при лимфоме, раке молочной железы, мастоцитомах. Исследования показали, что доксорубицин увеличивает выживаемость при раке молочной железы в два-четыре раза по сравнению с хирургией одной.
Вводится внутривенно, медленно. Препарат красного цвета — владельцы часто в шоке, видя красную жидкость в капельнице. Но это просто цвет препарата, не кровь, как некоторые думают.
Побочные эффекты: тошнота, рвота (управляется противорвотными препаратами), потеря аппетита (обычно временная). На больших кумулятивных дозах возможна кардиотоксичность (повреждение сердца), но это редко при ветеринарных протоколах.
Винкристин (Онковин)
Алкалоид барвинка. Вмешивается в построение микротубулей в раковых клетках, что приводит к их гибели.
Используется в комбинированных протоколах (CHOP, ACOP). Очень эффективен. Вводится внутривенно, медленно (2-3 минуты).
Побочные эффекты минимальны, если вводить правильно. Если вводить слишком быстро или если произойдёт экстравазация (вытекание из вены), возможен некроз тканей. Это почему техника введения критична.
Циклофосфамид (Эндоксан)
Алкилирующий агент. Вмешивается в ДНК раковых клеток.
Может вводиться внутривенно или перорально (таблетки). При пероральном введении требуется хорошая гидратация, потому что препарат может раздражать мочевой пузырь и вызвать цистит.
Побочные эффекты: желудочно-кишечные проблемы, потеря аппетита, рвота. При длительном применении возможен цистит с гематурией (кровь в моче).
Карбоплатин
Платиновый агент. Используется при рецидивирующем раке или когда другие препараты не сработали.
Нейтропения и анемия более вероятны с карбоплатином, чем с другими препаратами. Требует тщательного контроля крови.
Преднизолон
Глюкокортикостероид. Часто часть комбинированных протоколов. Помогает снять воспаление, уменьшить рвоту, улучшить общее состояние.
Может также использоваться в монотерапии при некоторых типах лимфомы, особенно у кошек, где он может дать временную ремиссию.
Другие препараты
Существуют и другие препараты:
- ломустин (CCNU),
- мелфалан,
- митоксантрон,
- винбластин,
- винорелбин,
- блеомицин,
- гемцитабин.
Они используются в специфических случаях, в зависимости от типа рака и ответа на первичное лечение.

Основные типы рака: когда химиотерапия работает лучше всего
Не все раки одинаково реагируют на химиотерапию. Некоторые опухоли очень чувствительны к цитостатикам, другие — резистентны. Вот основные типы, где химиотерапия доказала свою эффективность:
Лимфома
Лимфома — это наиболее распространённый рак у собак, составляя около 20% всех опухолей. Это рак лимфоцитов и лимфоидной ткани.
Без лечения: собаки живут четыре-шесть недель. Кошки — столько же.
С химиотерапией (CHOP протокол): собаки достигают ремиссии в 90% случаев. Медиана выживаемости — один год. 25% собак живут два и более лет. Это невероятно — мы продлеваем жизнь в четыре-пять раз, и животные находятся в ремиссии, без признаков болезни.
Для кошек результаты немного хуже. При мультидруговом протоколе 65% достигают ремиссии. Медиана выживаемости — семь месяцев. Но некоторые кошки, особенно те, которые достигли полной ремиссии, живут намного дольше — год, два года.
Интересный момент: при низкограднной лимфоме (медленно растущей) результаты ещё лучше. Медиана выживаемости кошек — полтора-два года. А с пероральной химиотерапией (таблетки) лечение становится ещё более удобным.
Когда пациент достигает ремиссии в шесть месяцев, мы можем остановить лечение. Животное остаётся под наблюдением, ежемесячные осмотры. Если рак вернётся, мы возобновляем лечение. Вторая ремиссия обычно короче, но всё ещё дает время.
Мастоцитома
Мастоцитома — это опухоль из тучных клеток. Очень распространена у собак, особенно у боксеров и бульдогов.
- Grade I (хороший прогноз): редко метастазирует, часто хирургия одна достаточна.
- Grade II (промежуточный прогноз): 20% метастазирует, может потребоваться химиотерапия.
- Grade III (плохой прогноз): 80% метастазирует, агрессивная, требует химиотерапии.
При Grade III мастоцитомах без лечения медиана выживаемости — 47 дней. Смертельно. С ACOP протоколом (доксорубицин, циклофосфамид, винкристин, преднизолон) медиана увеличивается до 106 дней. И, что главное, 27% животных живут шесть месяцев и дольше.
Это не излечение, но это время. И в этом время животное живет нормальной жизнью, с хорошим качеством.

Остеосаркома
Остеосаркома — это рак кости. Очень агрессивный. Обычно поражает длинные кости конечностей крупных собак. Золотистые ретриверы, немецкие овчарки, немецкие доги — они в группе риска.
- Причина, почему остеосаркома так опасна: она очень быстро метастазирует в лёгкие. Большинство собак имеют микрометастазы (невидимые метастазы) к моменту диагноза.
- Без лечения: несколько недель.
- С хирургией (обычно ампутация): четыре-пять месяцев.
- С хирургией и химиотерапией: семь-двенадцать месяцев. 20% собак живут два года и больше.
Это разница в месяцы. Месяцы, когда собака может бегать, играть, быть с семьей. После ампутации большинство собак адаптируются отлично. С химиотерапией мы боремся с невидимыми микрометастазами, предотвращая их рост.
Новое направление в лечении остеосаркомы — метрономная химиотерапия. Низкие дозы, длительное введение. Одна собака с остеосаркомой верхней челюсти прожила 193 недели (почти четыре года!) с комбинацией хирургии и метрономной химиотерапии. Это в 8-14 раз дольше, чем обычно.

Гемангиосаркома
Гемангиосаркома — это опухоль из клеток, выстилающих кровеносные сосуды. Очень агрессивная. Обычно поражает селезенку или сердце.
Проблема: она часто протекает без симптомов до поздней стадии. Потом опухоль разрывается, происходит внутреннее кровотечение, и животное падает. Это неотложная ситуация.
- Без лечения: около трёх месяцев (часто кровотечение происходит раньше).
- С спленэктомией (удаление селезенки): полтора-три месяца.
- С спленэктомией и химиотерапией: шесть-восемь месяцев. Некоторые собаки живут года.
Химиотерапия не спасает всех, но она даёт время, время на ценные моменты с питомцем.

Рак молочной железы: исход зависит от стадии
При раке молочной железы доксорубицин стал игрой-переломом. У кошек с раком молочной железы III стадии без лечения медиана выживаемости — несколько месяцев. С доксорубицином медиана выживаемости увеличивается до 8,3 месяцев до прогрессирования болезни.
Доксорубицин увеличивает выживаемость в два-четыре раза при раке молочной железы по сравнению с хирургией одной.
Почему я никогда не обещаю излечение
Когда я разговариваю с владельцем о химиотерапии, я никогда не обещаю излечение. Почти все раки у животных неизлечимы. Мы не можем полностью избавить животное от рака.
Но мы можем дать ему ремиссию. Мы можем замедлить рост опухоли. Мы можем дать ему месяцы, а иногда годы жизни с хорошим качеством.
И качество жизни — это моя главная цель. В ветеринарной онкологии мы имеем очень низкий порог для побочных эффектов. Если я вижу, что химиотерапия приносит животному больше вреда, чем пользы, я меняю препарат, снижаю дозу или вообще переходу на паллиативную помощь.
Большинство животных хорошо переносят химиотерапию. 83% собак имеют только лёгкие побочные эффекты (grade 1), которые не требуют вмешательства. Менее 5% требуют госпитализации из-за побочных эффектов.
Это совсем другая картина, чем в человеческой медицине, где химиотерапия часто вызывает сильные побочные эффекты. У людей цель — излечение, и они готовы терпеть. У животных цель — комфорт и время с семьей.

Побочные эффекты: реальны, но управляемы
Да, побочные эффекты происходят. Но они обычно мягче, чем люди ожидают.
Желудочно-кишечные побочные эффекты (30% животных)
- Рвота и тошнота. Это наиболее частый побочный эффект. Происходит в течение 24-72 часов после лечения. Обычно проходит за несколько дней. Я профилактически даю противорвотные препараты. Маропитант (Cerenia), метоклопрамид, фамотидин — выбор зависит от типа химиотерапевтического препарата.
- Диарея. Возможна, но менее частая, чем рвота. Рекомендуется лёгкая диета: отварная курица, рис, консервы для животных с чувствительным ЖКТ.
- Потеря аппетита. Животное может отказаться от еды на несколько дней. Обычно восстанавливается. Если длится дольше недели, может потребоваться вмешательство — мягкие вкусные продукты, возможно, стимуляторы аппетита.
Костномозговая супрессия (22% животных)
Это более серьёзная побочный эффект. Многие цитостатики воздействуют на быстро делящиеся клетки в костном мозге, включая клетки, которые производят белые кровяные клетки.
- Нейтропения (снижение лейкоцитов) — наиболее частая форма костномозговой супрессии. Обычно развивается на 6-10 день после лечения (это называется "наиром" — время наибольшего снижения). При нейтропении животное становится более восприимчивым к инфекциям. Если нейтропения тяжёлая (<500 клеток/μL), я даю антибиотики профилактически. Если нейтропения ещё тяжелее и сопровождается лихорадкой, это называется нейтропенической лихорадкой и требует госпитализации, внутривенных антибиотиков, жидкостей.
- Сепсис (заражение крови) может развиться, и это потенциально смертельно. Но это редко — менее 1% животных.
- Тромбоцитопения (снижение тромбоцитов, клеток, отвечающих за свёртываемость) — возможна, особенно при повторных лечениях. Признаки: петехии (маленькие кровоизлияния в коже), кровотечения из дёсен, кровь в моче или кале.

Другие побочные эффекты
- Потеря шерсти. Обычно у пород без линьки (терьеры, пудели, шнауцеры). Волосы становятся тусклыми, ломкими, могут выпадать. Обычно восстанавливаются после окончания лечения.
- Местные реакции. Если препарат вытечет из вены (экстравазация), возможен некроз тканей, флебит (воспаление вены). Это почему вводить эти препараты должен опытный ветеринар.
- Кардиотоксичность. При доксорубицине на больших кумулятивных дозах (>200 мг/м²) возможно повреждение сердца. Это редко при ветеринарных протоколах, но мы контролируем это, ограничивая кумулятивные дозы и иногда проводя эхокардиографию.

Как я управляю побочными эффектами
Если животное получает сильные побочные эффекты от химиотерапии, это не означает, что нужно остановить лечение. Это означает, что нужно изменить подход.
Несколько стратегий:
- Смена препарата. Если животное плохо переносит доксорубицин, я могу перейти на другой препарат, который может быть эффективен, но лучше переносится.
- Снижение дозы. Часто снижение дозы на 10-20% достаточно, чтобы побочные эффекты стали управляемыми, и при этом эффективность не очень страдает.
- Изменение интервала. Вместо еженедельного лечения могу перейти на лечение каждые две недели, давая животному больше времени на восстановление.
- Добавление поддерживающей терапии. Лучшие противорвотные препараты, пробиотики для кишечника, противозудные препараты, обезболивающие.
- Переход на метрономную химиотерапию. Это низкие дозы, часто пероральные (таблетки), которые животное может получать дома. Переносится намного лучше.
Мой философский подход: если химиотерапия вызывает сильные страдания, это не помощь, это вред. В этом случае паллиативная помощь (облегчение боли и дискомфорта) может быть лучшим вариантом.

Домашний уход и поддержка во время химиотерапии
Роль владельца критична для успешной химиотерапии. Вот что я рекомендую:
- Питание. Качественная, питательная еда. Не скупитесь на белок. Раковые клетки потребляют много энергии, и организм животного нуждается в достаточном питании для восстановления.
- Если животное теряет аппетит после лечения, предлагайте мягкие, вкусные продукты: отварная курица, рыба, специальные консервы для животных с чувствительным ЖКТ.
- Гидратация. Убедитесь, что животное пьёт достаточно воды. Можно предложить влажную пищу, бульон (без соли), льёд.
- Отдых. Дайте животному спокойное место для отдыха. В первые дни после лечения животное может быть вялым — это нормально. Не заставляйте его играть.
- Контроль температуры. Если животное получает лечение, которое может вызвать нейтропению, и у вас есть признаки лихорадки (температура выше 39,5°C), срочно свяжитесь с ветеринаром. Это может быть ранний признак инфекции.
- Контрольные визиты. Регулярные визиты ветеринара, анализы крови перед каждым лечением. Это не опционально — это необходимо для безопасности.
- Поддержка и наблюдение. Ведите дневник — как животное себя чувствует, как его аппетит, есть ли рвота, диарея. Это поможет ветеринару скорректировать лечение.

Метрономная химиотерапия: новое направление в лечении рака
Традиционная химиотерапия использует высокие дозы препаратов в отдельных сеансах (MTD — maximum tolerated dose, максимально переносимая доза).
Метрономная химиотерапия — это новое направление, которое использует низкие дозы препаратов, вводимых часто (например, ежедневно) или непрерывно.
Преимущества метрономной химиотерапии:
- Лучше переносится. Побочные эффекты намного мягче, потому что дозы низкие.
- Можно использовать дома. Часто это таблетки, которые владелец может давать дома, не нужно ездить в клинику каждую неделю.
- Антиангиогенный эффект. Низкие дозы предотвращают рост новых кровеносных сосудов, питающих опухоль, что замедляет её рост.
- Может комбинироваться с высокодозной химиотерапией. Вместе они часто более эффективны.
- Для продвинутых стадий. Используется, когда животное не может перенести высокодозную химиотерапию или опухоль резистентна к ней.
Примеры препаратов для метрономной химиотерапии:
- Циклофосфамид (таблетки, низкая доза)
- Доксорубицин (низкая доза, интравенозно)
- Карбоплатин (низкая доза)
Кейс ветеринара
Один из самых впечатляющих случаев — собака с остеосаркомой верхней челюсти, которая получала метрономную химиотерапию комбинированно с другими препаратами. Эта собака прожила 193 недели после хирургии (почти четыре года!), когда обычно выживаемость 7-12 месяцев.
Если вашей собаке или кошке диагностирован рак, не теряйте надежду. Поговорите с ветеринаром-онкологом. Узнайте о вариантах у ветеринаров клиники Laska Pets. Химиотерапия для животных может дать вам то, чего вы хотите больше всего — больше времени со своим питомцем.

